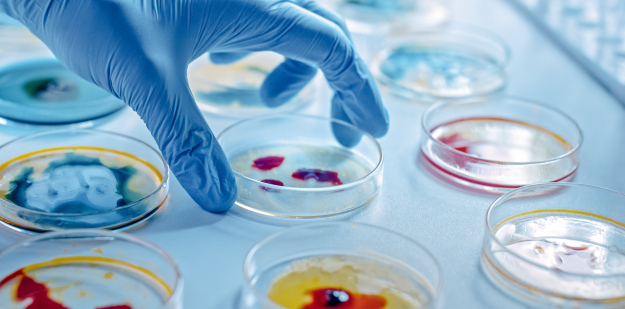

Tragiczne wieści… jest coraz gorzej?
BBC News potwierdza, że zaczynamy mieć do czynienia z „ukrytą pandemią”. Współczesna opieka medyczna musi mierzyć się z wyzwaniem, jakim są oporne na antybiotyki bakterie. Angielska stacja telewizyjna powołuje się na oświadczenie ministerstwa zdrowia Wielkiej Brytanii w tej sprawie. Specjaliści z uniwersytetu w Waszyngtonie podkreślają, że chodzi aż o 204 kraje, które zostały uwzględnione w raporcie.
Liczby nie kłamią
Naukowcy wyliczyli, że w 2019 roku zmarło 5 mln pacjentów w wyniku chorób, do których przyczyniły się zakażenia bakteryjne, odporne na antybiotyki. Uczeni oszacowali, że infekcje bateryjne były bezpośrednią przyczyną śmierci w przypadku 1,9 mln chorych. Dla porównania – w tym samym roku – wirus AIDS, spowodował zgony 860 tys. osób. Natomiast choroba pasożytnicza malaria uśmierciła 640 tys. pacjentów.
O jakich bakteriach mowa?
- Okazuje się, że głównym czynnikiem, wywołującym zakażenia bakterii opornych na działanie antybiotyków , są infekcje dróg oddechowych, między innymi zapalenie płuc oraz sepsa, zakażająca krew.
- Najniebezpieczniejsza wydaje się bakteria MRSA, mianowicie gronkowiec złocisty, który jest oporny na metycylinę.
- Częstym powodem infekcji bakteryjnych są zakażenia szpitalne.
- Groźne są również niektóre szczepy E.coli (pałeczka okrężnicy), które wytworzyły odporność na działanie antybiotyków.
Kto jest najbardziej zagrożony?
Niestety z raportu wynika, że co piąty zgon z powodu antybiotykoodpornych bakterii następuje u dziecka. Bowiem, to właśnie najmłodsi pacjenci są najbardziej podatni na zakażenia bakteryjne. Szacuje się, że najwięcej dzieci umiera w Afryce Subsaharyjskiej i Azji południowej – aż 24 zgony na 100 tys. mieszkańców. Natomiast najmniej w bogatych krajach, to 13 zgonów na 100 tys. mieszkańców.
Metody zwalczania problemu
Eksperci podkreślają, że trzeba jak najszybciej podjąć działania. Gdyż należy zwiększyć dostępność środków przeznaczonych do zwalczania zakażeń bakteryjnych. Nawet nie chodzi o opracowanie i stworzenie nowych leków przeciwbakteryjnych. Najpierw warto zapewnić właściwe wykorzystanie, istniejących już antybiotyków, tak aby zapobiec dalszym zakażeniom.
Źródło: PAP, BBC News, The Lancet
Czytaj też: